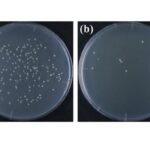
revealing-new-discoveries-in-x-ray-sterilization:-the-crucial-role-of-dose-rate

A groundbreaking advancement in the field of robotics has emerged from the laboratories of Shandong University, where researchers have developed a cutting-edge framework to coordinate motion distribution and tracking for quadruped manipulators. This innovation holds immense promise for enhancing the agility and dexterity of legged robots, which combine animal-like locomotion with sophisticated manipulation abilities, enabling them to operate effectively in complex and unpredictable environments. The research, recently published in the prestigious journal Cyborg and Bionic Systems, elucidates a novel multi-task prioritization algorithm combined with null-space projection techniques to seamlessly manage the robot’s multiple degrees of freedom.
At the core of this pioneering approach lies a concerted effort to overcome the inherent challenges faced by quadruped manipulators, such as redundancy in motion planning and the necessity to balance multiple competing objectives simultaneously. Legged robots equipped with manipulator arms must not only traverse rough terrain with stability but also perform precise manipulation tasks, which demands intricate coordination of their locomotion and arm motion capabilities. The proposed framework ingeniously splits these tasks into a hierarchy of prioritized objectives, allowing the robot’s control system to dynamically generate optimal motion commands that satisfy critical requirements without sacrificing overall performance.
The framework’s architecture builds upon a sophisticated whole-body control (WBC) system that incorporates detailed dynamic models, inverse kinematics calculations, and multi-objective optimization strategies. By adopting the methodology of Murphy et al. for system simplification, the researchers successfully model the complex kinematics and dynamics of quadruped manipulators, treating the robot’s base as an extension of the manipulator’s joints. This unified perspective enables the controller to holistically consider the interplay between leg movements and arm actions, thus optimizing the robot’s global motion strategy.
One of the standout features of this framework is its novel use of null-space projection derived from established saturation-in-null-space algorithms, originally proposed by Flacco and colleagues. This mathematical strategy facilitates the resolution of redundant degrees of freedom by projecting secondary tasks into the null space of primary task constraints, effectively redistributing motion commands without conflicting with the robot’s fundamental objectives. By extending this principle to quadruped manipulators, the researchers have enabled the system to adaptively prioritize trajectory tracking of the end-effector, redistribute motions to adhere to physical limitations, and optimize the robot’s manipulability, all in a coordinated manner.
The entire process unfolds through a three-tiered task hierarchy. The foremost priority is maintaining precise trajectory tracking of the end-effector—typically the bionic arm—ensuring that manipulation tasks are executed with minimal deviation. Next in importance is motion redistribution, wherein the framework judiciously reallocates joint movements within the null space to enhance tracking accuracy and enforce constraints such as joint limits and torque boundaries. Finally, a compensation velocity is introduced as a tertiary task to mitigate the risks of singularities in the robotic system’s configuration, thereby preventing performance degradation or control instability.
Integral to the successful operation of the framework is its reliance on advanced sensing capabilities. The implementation incorporates a tracking camera system coupled with an environment perception algorithm, providing real-time spatial awareness to inform motion decisions. This sensory input is crucial for enabling the robot to react compliantly to external interactions and adapt its motions accordingly, a necessity for navigating unstructured and dynamic environments often encountered in real-world applications.
Extensive validation of the framework was conducted through both simulation and physical experiments, underscoring its robustness and precision. The robotic platform demonstrated consistent operational space control, achieving end-effector tracking errors within a remarkable margin of less than three centimeters. This level of accuracy signals a major leap forward for quadruped manipulators, positioning them as viable solutions for complex tasks in hazardous, confined, or otherwise challenging environments.
The researchers envision numerous exciting enhancements on the horizon. Future iterations of the system aim to facilitate online manipulation trajectory planning, enabling the robot to autonomously adapt its motion strategies in response to changing task demands. Furthermore, by integrating vision-based object recognition, the manipulator will be capable of autonomously grasping and manipulating objects, pushing the boundaries of robotic autonomy. Ambitious goals also include extending the algorithm for applications in confined space manipulation and dynamic object catching, potentially utilizing reinforcement learning techniques to imbue the robot with adaptive skills akin to biological organisms.
This innovative research is steered by lead scientist Aizhen Xie, alongside a dedicated team comprising Xuewen Rong, Guoteng Zhang, Yibin Li, Yong Fan, Zhi Li, and Teng Chen. Their concerted efforts were supported by eminent Chinese scientific funding bodies such as the National Key Research and Development Program of China and the National Natural Science Foundation of China, alongside regional initiatives focused on advancing technological innovation within medium and small-sized enterprises.
The full exposition of this research can be found in the article titled “Prioritized Multi-task Motion Coordination of Physically Constrained Quadruped Manipulators,” which was officially published on March 19, 2025, in Cyborg and Bionic Systems. This paper delineates the theoretical underpinnings, algorithmic formulations, and experimental validations in detail, offering a comprehensive resource for researchers and practitioners aiming to push the frontiers of legged robotic manipulation.
By addressing the intricacies of motion distribution and task prioritization in a physically constrained quadruped robot, this work paves the way toward more capable, adaptable, and intelligent legged machines. It holds great potential for deployment across a spectrum of domains including search and rescue, environmental monitoring, agriculture, and industrial automation, where robots must traverse complex terrains and perform delicate manipulation tasks with both strength and finesse. The fusion of control theory, dynamic modeling, and cutting-edge sensing embedded within this framework marks a landmark in robotic systems design.
As robotics continues its rapid evolution, frameworks such as this underscore the transformative possibilities achievable by harmonizing multi-disciplinary innovations. The confluence of advanced kinematics, whole-body control, and perception-based feedback exemplifies the future trajectory for robotics—a future where machines seamlessly integrate locomotion and manipulation, exhibiting fluidity and adaptability comparable to living creatures. The path charted by the Shandong University team promises to inspire further breakthroughs that will embed robotic systems ever more deeply into productive and beneficial roles throughout society.
Subject of Research: Motion coordination and control of quadruped manipulators with high degrees of freedom using multi-task prioritization and null-space projection techniques.
Article Title: Prioritized Multi-task Motion Coordination of Physically Constrained Quadruped Manipulators
News Publication Date: March 19, 2025
Web References: DOI: 10.34133/cbsystems.0203
Image Credits: Aizhen Xie, Shandong University
Keywords: Applied sciences and engineering, Health and medicine
Tags: advanced robotics algorithmsanimal-like locomotion in roboticscomplex environment navigationdynamic motion command generationlegged robot dexteritymanipulation tasks for legged robotsmulti-task motion planningphysically constrained manipulatorsprioritization in robotic control systemsquadruped robot motion coordinationredundancy management in motion planningShandong University robotics research